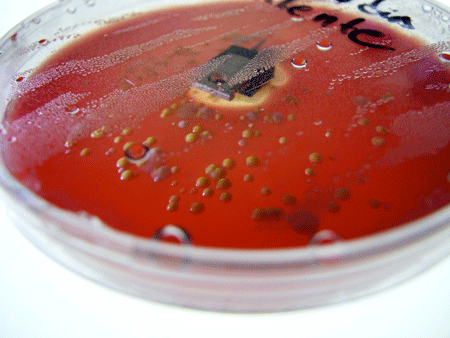
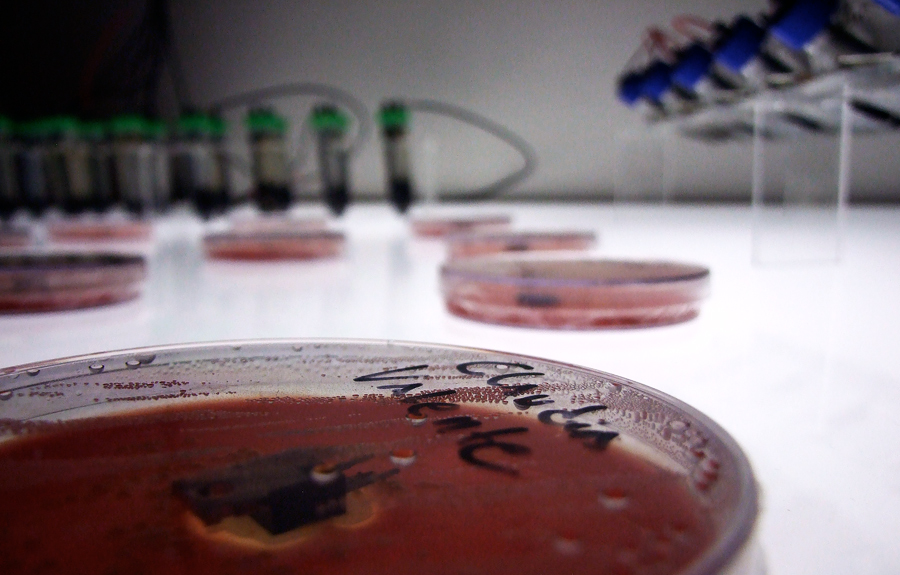

"Colonia (lab)" - Instalación Laboratorio - 2015/16
¿Cual es la génesis de un proyecto artístico que propone una experiencia que tiende a vivenciar comportamientos presentes en la constitución de organismos vivos?. Desde este disparador se presenta esta bio-instalación sonora formada por una colonia de seres constituidos por partes tecnológicas en desuso y bio-unidades de material orgánico en descomposición. Estas unidades producen energía que controlan la frecuencia de oscilación sonora de cada pieza de la colonia independiente. El conjunto de piezas-organismo funciona como un único cuerpo sonoro que fluctúa en el espacio expositivo, producto de las cancelaciones y sumatorias de las diferentes mini variaciones en la oscilación que cada pieza produce independientemente. La pregunta inicial parte de una investigación sobre la problemática de lo vivo (literalmente) en los proyectos de arte tecnológico, las preocupaciones sobre el valor de verdad en la ciencia y los alcances del concepto de lo autónomo como expresión de lo que es independiente de un autor o creador. Desde estas miradas, cobra sentido también la idea de laboratorio de artista como lugar de gestación de lo semi-científico. Estos espacios se presentan como lugares imperfectos, por momentos serios, por momentos lúdicos. Un proyecto como “Colonia (lab)” se nutre de ellos y pone en juego todos estos elementos, intentando repensar lo que consideramos pilares establecidos desde la ciencia y desde el arte.
Agradecimientos: UNTREF / Vet. Gabriel Cicuttin / Claudia Valente / Buba Traore / Juan Manuel Quesada / Kevin Kripper / Marlin Velasco / Sebastian Pasquel / Claudio Campos Kray / Gabriela Munguía / Augusto Zanela / Walter Arias